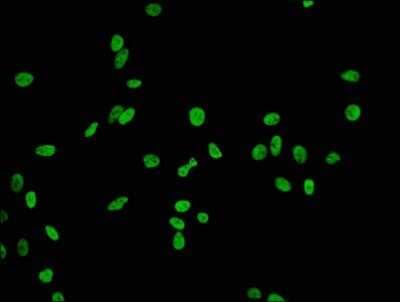

Histone H2B type 1B [ac Lys20] Antibody (21F11) - BSA Free
Novus Biologicals, part of Bio-Techne | Catalog # NBP3-15229
Recombinant Monoclonal Antibody

Key Product Details
Validated by
Biological Validation
Species Reactivity
Human
Applications
Western Blot, ELISA, Flow Cytometry, Immunocytochemistry/ Immunofluorescence
Label
Unconjugated
Antibody Source
Recombinant Monoclonal Rabbit IgG Clone # 21F11 expressed in HEK293
Format
BSA Free
Concentration
Please see the vial label for concentration. If unlisted please contact technical services.
Product Specifications
Immunogen
A synthesized peptide. UniProt ID (P33778).
Modification
ac Lys20
Clonality
Monoclonal
Host
Rabbit
Isotype
IgG
Description
Novus Biologicals Rabbit Histone H2B type 1B [ac Lys20] Antibody (21F11) - BSA Free (NBP3-15229) is a recombinant monoclonal antibody validated for use in WB, ELISA, Flow and ICC/IF. All Novus Biologicals antibodies are covered by our 100% guarantee.
Scientific Data Images for Histone H2B type 1B [ac Lys20] Antibody (21F11) - BSA Free
Western Blot: Histone H2B type 1B [ac Lys20] Antibody (21F11) [NBP3-15229] - Positive WB detected in Hela whole cell lysate treated by 15mM sodium butyrate for 30 minutes. All lanes: Histone H2B type 1B antibody at 0.135ug/ml. Secondary: Goat polyclonal to rabbit IgG at 1/50000 dilution. Predicted band size: 15 KDa. Observed band size: 15 KDa.
Immunocytochemistry/Immunofluorescence: Histone H2B type 1B [ac Lys20] Antibody (21F11) [NBP3-15229] - Immunofluorescence staining of Hela cells (treated by 15mM sodium butyrate for 30 minutes) with at Histone H2B type 1B antibody 1:84, counter-stained with DAPI. The cells were fixed in 4% formaldehyde, permeabilized using 0.2% Triton X-100 and blocked in 10% normal Goat Serum. The cells were then incubated with the antibody overnight at 4C.The secondary antibody was Alexa Fluor 488-congugated Goat Anti-Rabbit IgG (H+L).
Flow Cytometry: Histone H2B type 1B [ac Lys20] Antibody (21F11) [NBP3-15229] - Overlay histogram showing Hela cells stained with Histone H2B type 1B antibody (red line) at 1:50. The cells were fixed with 70% Ethylalcohol (18h) and then permeabilized with 0.3% Triton X-100 for 2 min.The cells were then incubated in 1x PBS /10% normal goat serum to block non-specific protein-protein interactions followed by primary antibody for 1 h at 4C.The secondary antibody used was FITC goat anti-rabbit IgG (H+L) at 1/200 dilution for 1 h at 4C. Control antibody (green line) was used under the same conditions. Acquisition of >10,000 events was performed.
Applications for Histone H2B type 1B [ac Lys20] Antibody (21F11) - BSA Free
Application
Recommended Usage
Flow Cytometry
1:50-1:500
Immunocytochemistry/ Immunofluorescence
1:30-1:200
Western Blot
1:5000-1:10000
Formulation, Preparation, and Storage
Purification
Affinity purified
Formulation
PBS, pH 7.4, 150mM NaCl, and 50% glycerol
Format
BSA Free
Preservative
0.02% Sodium Azide
Concentration
Please see the vial label for concentration. If unlisted please contact technical services.
Shipping
The product is shipped with polar packs. Upon receipt, store it immediately at the temperature recommended below.
Stability & Storage
Store at -20 to -70C. Avoid freeze-thaw cycles.
Background: Histone H2B type 1B
Alternate Names
H2B histone family, member F, H2B/fHistone H2B.f, H2BFFH2B.1, histone 1, H2bb, histone cluster 1, H2bb, histone H2B type 1-B, Histone H2B.1, MGC119804
Gene Symbol
H2BC3
Additional Histone H2B type 1B Products
Product Documents for Histone H2B type 1B [ac Lys20] Antibody (21F11) - BSA Free
Product Specific Notices for Histone H2B type 1B [ac Lys20] Antibody (21F11) - BSA Free
This product is for research use only and is not approved for use in humans or in clinical diagnosis. Primary Antibodies are guaranteed for 1 year from date of receipt.
Loading...
Loading...
Loading...
Loading...
Loading...